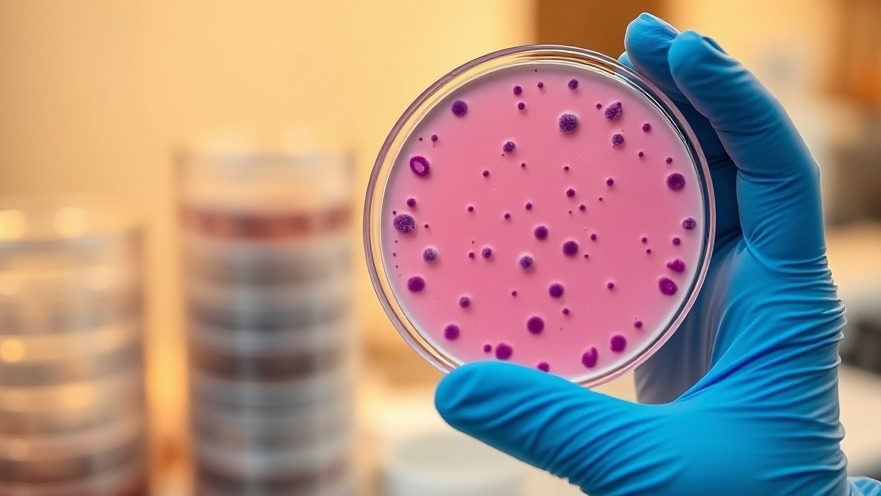
Streptococcal Infections: Understanding Risks and Prevention for Your Practice

Understanding Streptococcal Infections: The Basics
Streptococcal infections are caused by the bacterium species known as Streptococcus, which presents a variety of health challenges ranging from common ailments like strep throat to more severe complications such as pneumonia and bloodstream infections. For concierge medical practice owners, understanding these infections is vital, not only to provide accurate diagnoses but also to foster meaningful health conversations with patients about prevention and effective treatment strategies.
The Broad Spectrum of Streptococcal Infections
While most people associate streptococcal infections with strep throat, the virulent Group A Streptococcus (S. pyogenes) can lead to grave health issues, including necrotizing fasciitis and rheumatic fever. Each group of streptococci can produce specific disorders; for example, Group B Streptococcus (S. agalactiae) significantly impacts newborns and pregnant women, while Viridans streptococci have been connected to dental health issues and endocarditis.
A Quick Guide to Symptoms and Diagnosis
Identifying streptococcal infections can be a challenge because symptoms often overlap with viral infections. Common signs include a sore throat, swollen lymph nodes, and headache. For patients, timely evaluation is critical, as untreated strep throat can escalate into rheumatic fever, a dangerous condition with long-term consequences. Therefore, doctors must rely on throat swab cultures and rapid tests to conclusively diagnose these infections.
According to the Mayo Clinic, symptomatic patients should be instructed to seek medical attention for sore throats that last longer than 48 hours accompanied by fever or rash.
Effective Treatment and Prevention Strategies
For most streptococcal infections, antibiotics—usually penicillin—are the recommended treatment. They not only shorten the duration of symptoms but also prevent serious complications like heart disease. Concierge medical practices should emphasize the importance of prompt antibiotic administration and patient education regarding infection prevention. Washing hands, covering coughs, and not sharing personal items are pivotal in reducing transmission.
Fostering Patient Relationships Through Education
As a concierge medical practice owner, it is imperative to communicate effectively with patients about the implications of streptococcal infections. Utilizing educational materials can help your patients better understand health risks, foster trust, and encourage proactive health management. There is also value in discussing potential complications like PANDAS, a condition associated with strep infections that may affect children's neuropsychiatric health.
Mental Wellness and Patient Care
Aside from physical health, addressing mental health in the context of infections can enhance overall patient well-being. Recognizing the psychological impact of illness—such as anxiety about strep complications—can lead to a more compassionate practice that values holistic health improvements. This promotes a deeper connection between you and your patients, establishing your practice as a key player in both their physical and mental wellness.
Your Next Steps as a Care Provider
It’s essential to stay informed about the latest treatment guidelines and prevention strategies for streptococcal infections. Providing comprehensive care encompassing both physical and emotional health will aid in securing your position as the top local medical concierge practice. Continuous education and empathetic communication can help cement long-lasting relationships with your patients, ultimately leading to improved health outcomes in your community.





Write A Comment